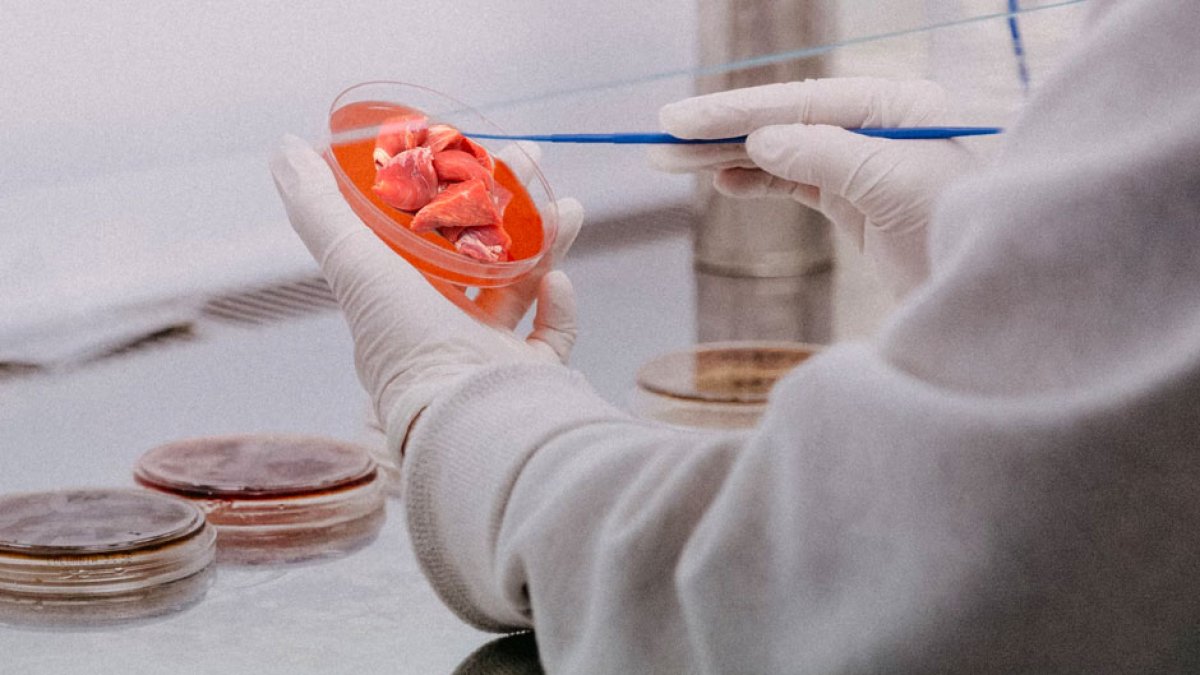
(Unsplash)

El USDA aprobó el consumo de carne de pollo cultivada en laboratorios
Estados Unidos es el único país del mundo junto a Singapur que acepta la venta y el consumo de este tipo de producto.
(Unsplash)
Este miércoles el Departamento de Agricultura (USDA) aprobó la venta al público de pollo elaborado en un laborado a partir de células animales, lo que convierte a Estados Unidos en el segundo país de todo el mundo en permitir esta alternativa.
Upside Foods y Good Meat, productores de la carne “cultivada” anunciaron este miércoles a través de sus redes sociales que recibieron su última aprobación para la producción y venta de este producto.
Esta decisión convertirá a Estados Unidos en ser el único país del mundo detrás de Singapur en permitir la venta de este producto creado con células extraídas del cuerpo de un animal y producido en grandes tanques de acero.
“Esta aprobación final significa que Good Meat es declarada segura para comer y producir en los Estados Unidos, marcando un momento innovador para la carne cultivada”, manifestó la empresa.
Los productores aseguran que esta es una propuesta busca que con la tecnología se puedan crear productos cárnicos consumibles como opción para eliminar el daño a los animales y reducir los impactos ambientales.
“En lugar de toda esa tierra y toda esa agua que se usa para alimentar a todos estos animales que son sacrificados, podemos hacerlo de una manera diferente”, dijo Josh Tetrick, cofundador y director ejecutivo de Good Meat.
Costos más elevados
A pesar del optimismo de los productores de pollo “cultivado”, la venta de esta nueva carne de laboratorio podría no ser tan fácil de vender debido a que los costos de producción son mucho más altos que las opciones tradicionales.
La preocupación de los expertos
Varios expertos han manifestado que los productores de carnes de laboratorio podrían estar exagerando la realidad sobre lo viable que es cultivar la proteína animal. De acuerdo al profesor Ricardo San Martín, que dirige el laboratorio de carnes alternativas en la escuela de ingeniería de Berkeley, hacer cantidades más grandes tiende a multiplicar exponencialmente los problemas, desde células necróticas hasta infecciones virales.
“Nadie ha aumentado la producción hasta el punto de poder producir la carne a un precio competitivo”, opinó Harini Venkataraman, analista del sector de la carne a base de células.
El chef Andrew Gruel también escribió a través de sus redes sociales que la carne cultivada en laboratorios representa un peligro “tanto para nuestro sistema alimentario como para nuestra economía. La energía necesaria para su producción es escandalosa: sólo puede sobrevivir gracias a las subvenciones del gobierno. Está llena de aditivos y no imita en absoluto las cualidades saludables de la carne”.